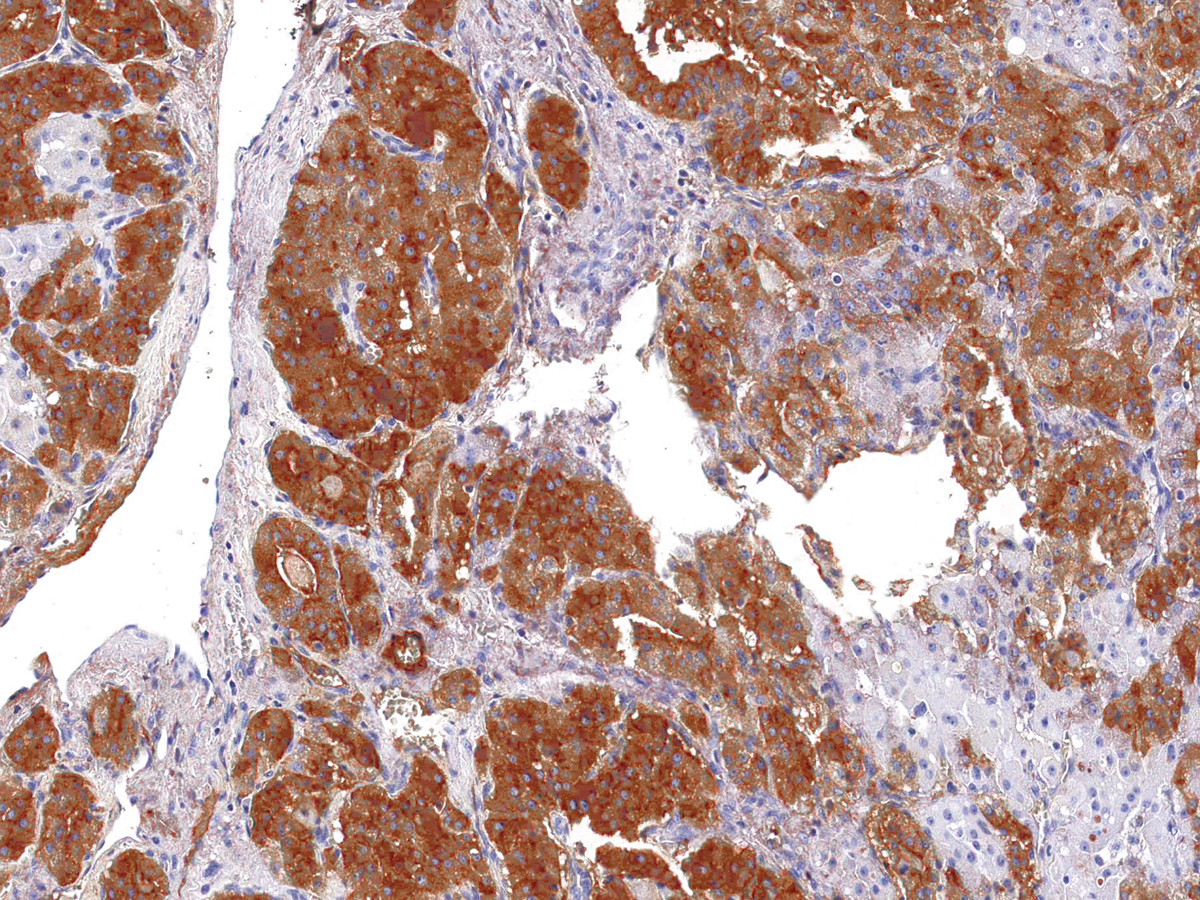
产品细节图片1

相关产品推荐更多 >
万千商家帮你免费找货
0 人在求购买到急需产品
- 详细信息
- 文献和实验
- 技术资料
- 形态:
liquid
- 保存条件:
Store at -20˚C
- 克隆性:
Monoclonal
- 适应物种:
Human
- 保质期:
12 months
- 抗原来源:
Mouse
- 供应商:
南京赛戈巍生物科技有限公司
- 宿主:
Mouse
- 应用范围:
IHC
- 抗体英文名:
Thyroglobulin Antibody
- 规格:
50ul/100ul
应用详情:Recommended working dilution range:1:100 - 1:200
图片:
Thyroglobulin [P1054] on Thyroid Cancer
风险提示:丁香通仅作为第三方平台,为商家信息发布提供平台空间。用户咨询产品时请注意保护个人信息及财产安全,合理判断,谨慎选购商品,商家和用户对交易行为负责。对于医疗器械类产品,请先查证核实企业经营资质和医疗器械产品注册证情况。
文献和实验脊椎动物甲状腺中大量存在的特异的含碘蛋白质。作为甲状腺激素的甲状腺素3, 5, 3′ -三碘甲腺原氨酸,是甲状腺内这种蛋白的酪氨酸残基经碘化所生成的碘化酪氨酸的两个残基,进一步缩合而生成的。这类激素需经蛋白酶作用于甲状腺球蛋白,使其变成游离态释放于血液中。由此可见,甲状腺球蛋白是甲状腺激素生成的场所,另也起着贮存型分子的作用。分子量约为 67万,等电点为 pH4.5左右。由于种属的不同,具有含碘量不相同的各种分子,其含量为 0.2-1%。除上述两种甲状腺激素含碘氨基酸残基外,还有二碘
Methods of Measuring Thyroglobulin and Peptide-Methylcoumarinamide Hydrolysis by Autoantibodies
Polyclonal antibodies often serve as the starting point for interesting studies of new antibody functions and their links with immunoregulation and autoimmune disease. For example, the catalytic activity of naturally formed antibodies
ELISA原理与实验方法The advantages of the ELISA are similar to other antibody-labeled reactions which include specificity, sensitivity, inexpensiveness, and safety. Since the enzyme label is the critical portion of ELISA, its selection is very important
技术资料暂无技术资料 索取技术资料





![PDCD7 Conjugated Antibody[C56981]](https://img1.dxycdn.com/p/s14/2025/0922/632/2321321568067599691.jpg!wh200)
![COL1A1 Rabbit Polyclonal Antibody[54314]](https://img1.dxycdn.com/p/s14/2025/0922/498/0460884283108299691.jpg!wh200)
![RNASE3 Conjugated Antibody[C36432]](https://img1.dxycdn.com/p/s14/2025/0923/278/4431488150116040791.jpg!wh200)
![HNRNPH1 Antibody[37625]](https://img1.dxycdn.com/p/s14/2025/0922/359/6146153295428599691.jpg!wh200)
